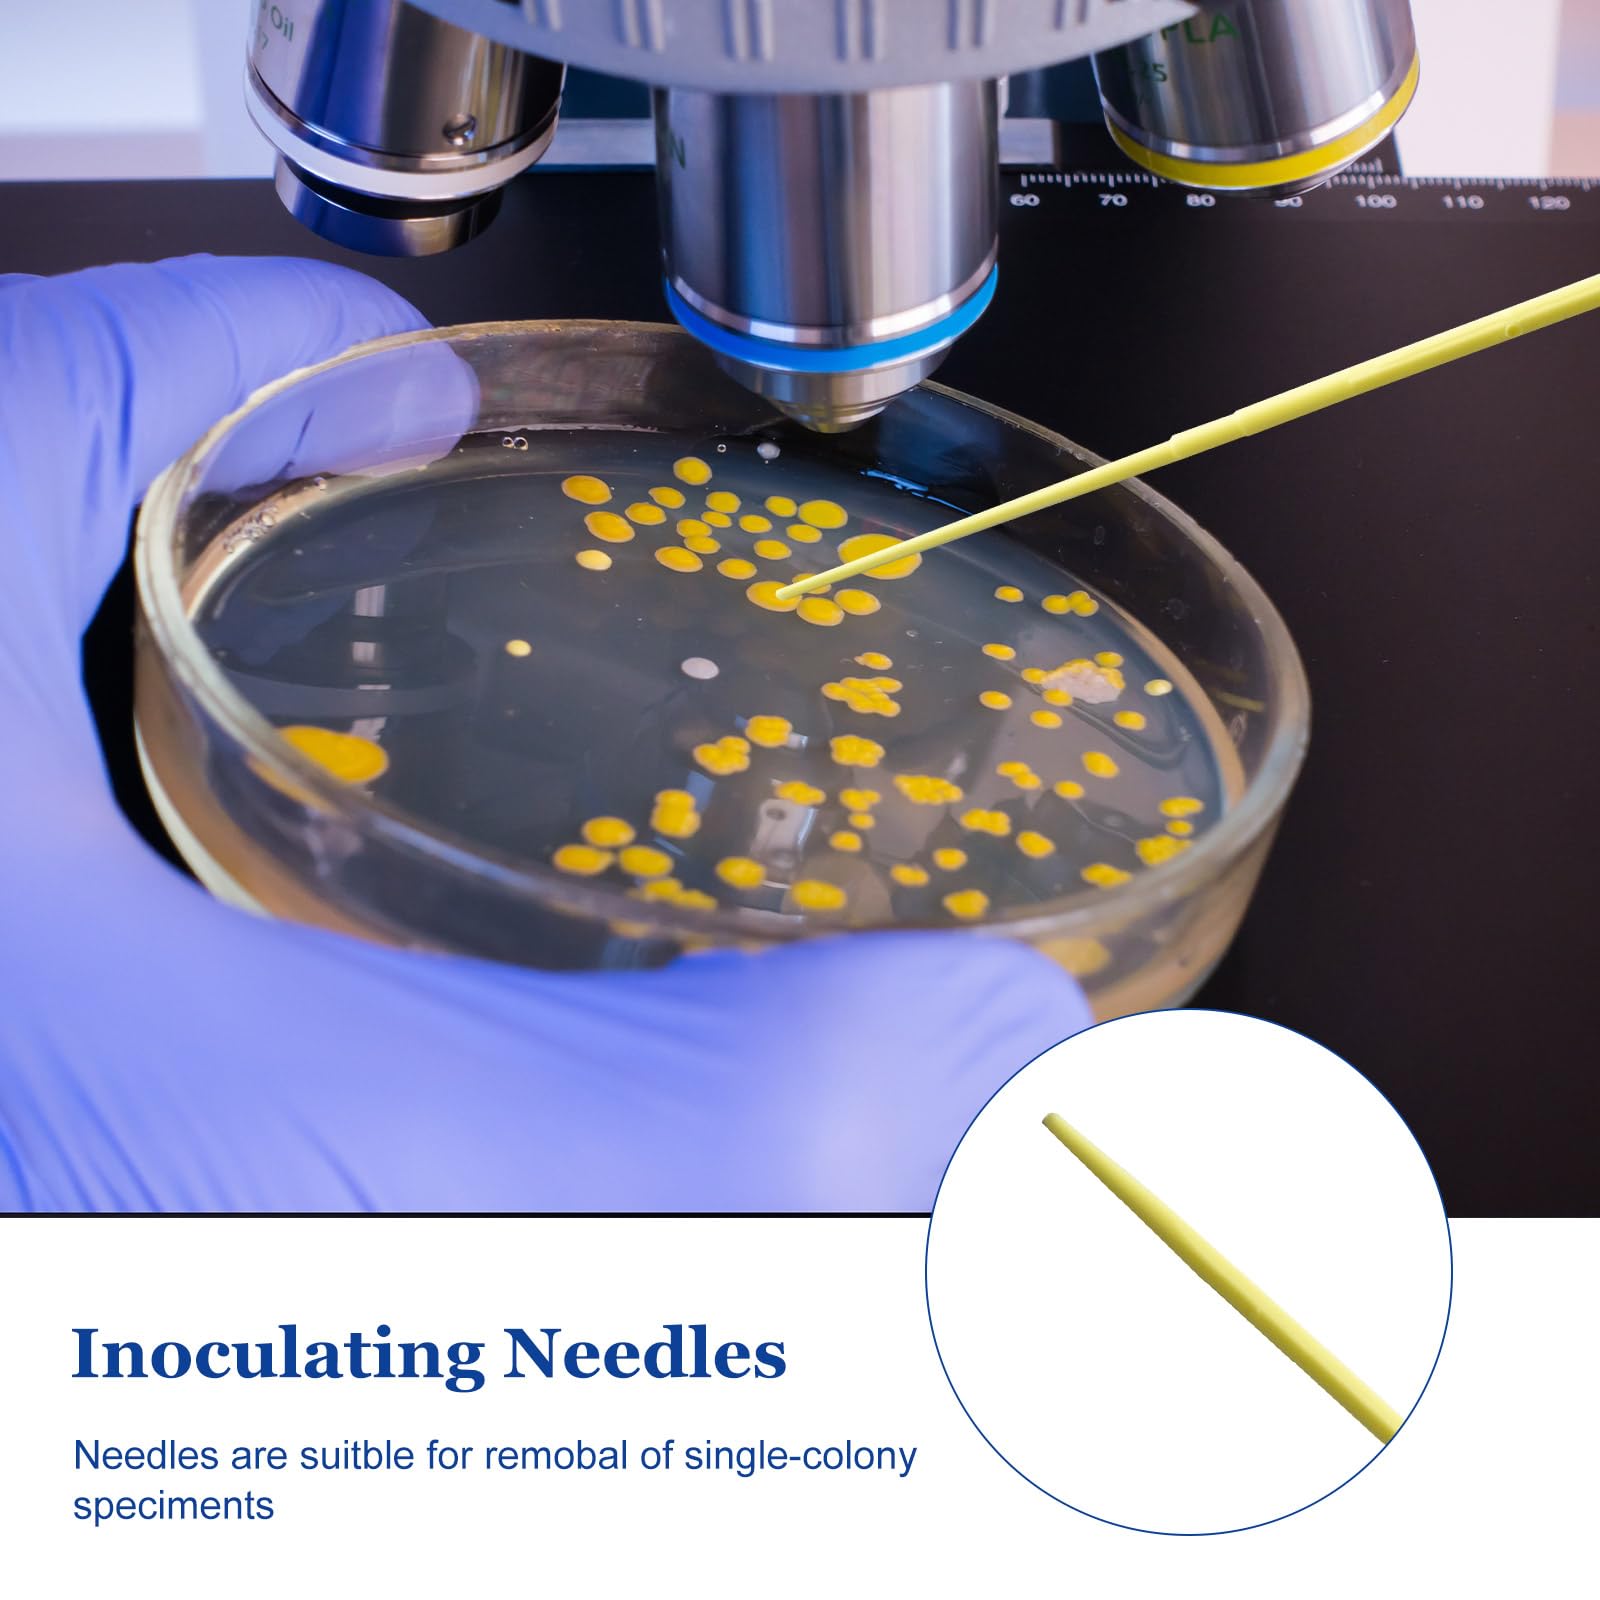
Thumbnail 5

🧪 Elevate your lab game with sterile precision and flexible control!
The Biologix 1000PCS Disposable Inoculating Needles feature gamma sterilization for contamination-free use, flexible polystyrene tips for precise single-colony specimen removal, and an ultra-smooth surface to protect cell integrity, making them an essential tool for professional microbiology and medical labs.





Trustpilot
2 days ago
3 weeks ago